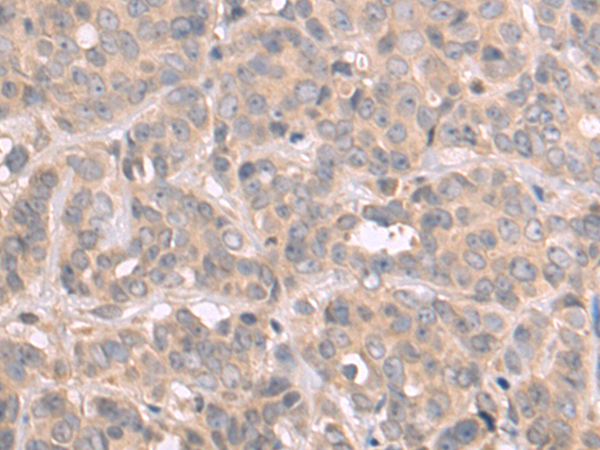
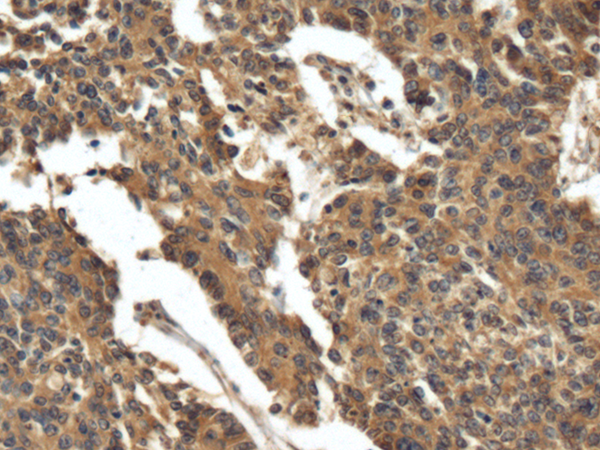
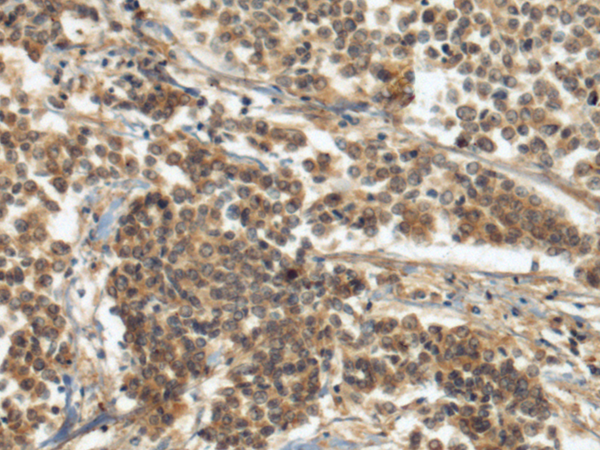
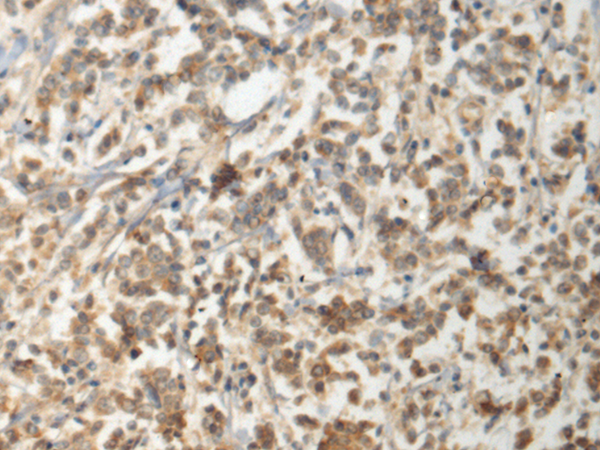

-
分类: 科研抗体货号: P10474别名: FKBP-3; FKBP25; PPIase; FKBP-25应用: WB,IHC反应种属: Human, Mouse
-
分类: 科研抗体货号: P10456别名: AFT; MTr2; HMTr2; FTSJD1应用: IHC反应种属: Human
-
分类: 科研抗体货号: P10473别名:应用: IHC反应种属: Human, Mouse, Rat
-
分类: 科研抗体货号: P10455别名: GBE; APBD; GSD4应用: IHC反应种属: Human, Mouse
-
分类: 科研抗体货号: P10472别名:应用: IHC反应种属: Human, Mouse
-
分类: 科研抗体货号: P10452别名: IPS; INO1; INOS; IPS 1; IPS-1应用: WB,IHC反应种属: Human, Mouse, Rat
-
分类: 科研抗体货号: P10471别名: BLP; BITH; DNCL2A; DNLC2A; ROBLD1应用: IHC反应种属: Human, Mouse, Rat
-
分类: 科研抗体货号: P10451别名: G6S应用: WB,IHC反应种属: Human, Mouse
-
分类: 科研抗体货号: P10470别名: ILBP; I-15P; I-BAP; ILBP3; ILLBP; I-BABP; I-BALB应用: WB,IHC反应种属: Human, Mouse
-
分类: 科研抗体货号: P10450别名: GDE3; OBDPF应用: WB,IHC反应种属: Human, Mouse

鄂公网安备42018502007531号
鄂公网安备42018502007531号

